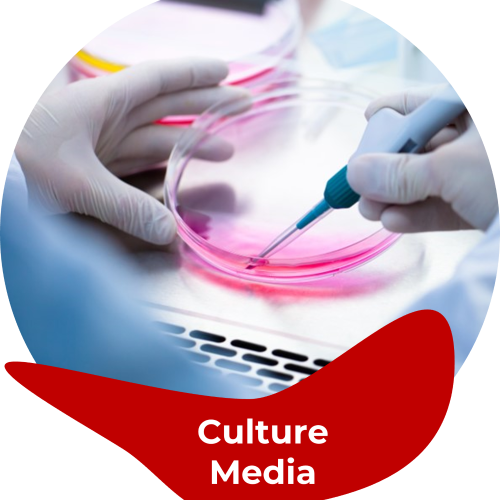
Cell Culture Media, Bulk, for Medium- to Large-Scale

Showing 97–112 of 515 resultsSorted by latest
-
ISO and cGMP Custom Manufacturing
Cell Culture Media, Bulk, for Medium- to Large-Scale
-
ISO and cGMP Custom Manufacturing
WFI and other High Grade Water Solutions
-
ISO and cGMP Custom Manufacturing
IVD Reagents
-
IVT Enzymes
In Vitro Transcription Enzymes
-
Buffers and Liquids
Buffers for Manufacturing and OEM